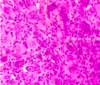

Histo: Neoplastic Bone Disease Flashcards
(39 cards)
Which part of the body is most commonly affected by neoplastic bone disease?
Around the knee joint
Outline some presenting features of neoplastic bone disease.
- Pain
- Swelling
- Deformity
- Fracture
How are bone tumours diagnosed
X-ray
Biopsy
What type of biopsy is often used for diagnosing neoplastic bone disease?
- Needle biopsy using a Jamshidi needle under CT or US guidance
- Open biopsy for sclerotic or inaccessible lesions
List some tumour-like conditions of the bone.
- Fibrous dysplasia
- Metaphyseal fibrous cortical defect/non-ossifying fibroma
- Reparative giant cell granuloma
- Ossifying fibroma
- Simple bone cyst
What is fibrous dysplasia? Which age does it affect? What bone does it affect?
- Condition in which fibrous tissue replaces normal bone tissue
- Can occur in any bone but ribs and proximal femur is most common
- Tends to affect adolescents
Which eponymous syndrome is characterised by polyostotic fibrous dysplasia?
McCune Albright Syndrome: polyostotic fibrous dysplasia + endocrine problems + rough border café-au-lait spots
Which mutation causes fibrous dysplasia?
GNAS mutation Chr 20 q13 (mutation in a G-protein)
Describe the histological appearance of fibrous dysplasia.
The marrow is replaced by fibrous stroma with rounded trabecular bone (‘Chinese letters’)

Describe the deformity seen on X-ray of fibrous dysplasia of the femoral head. What other lesion might you see?
Shepherd’s crook deformity
Soap bubble appearance of lytic lesions

List three types of cartilaginous benign bone tumour.
- Osteochondroma
- Enchondroma
- Chondroblastoma
List three types of bone-forming benign bone tumour.
- Osteoid osteoma
- Osteoma
- Osteoblastoma
What are osteochondromas and which bones tend to be affected?
- A benign overgrowth of cartilage and bone that tends to happen at the ends of long bones
- Most common site is distal end of femur
- They mimic normal tubular bone as they have a cartilaginous surface overlying normal trabecular bone

What is an enchondroma and which bones tend to be affected? What may an XR show?
- A cartilaginous proliferation within the bone
- Most tend to be found in the hands and can cause pathological fractures
- X-ray may show popcorn calcification

What are two macroscopic features of benign bone tumours?
- Well demarcated
- May erode through the cortex of bone but does not burst through the cartilaginous surface

What are giant cell tumours? Where do they tend to be found and what is their histological appearance?
- Benign tumour of the bone characterised by the presence of lots of osteoclast giant cells
- They tend to be found at the ends of long bones (epiphysis)
- It has a lytic appearance on X-ray
- Histology shows many osteoclasts on a background of spindle/ovoid cells
- Borderline malignancy - locally aggressive, can metastasise
What is the most common type of malignant bone tumour?
Metastases
Which cancers in adults tend to spread to the bone?
- Breast
- Prostate
- Lung
- Kidney
- Thyroid
Which cancers in children tend to spread to the bone?
- Neuroblastoma
- Wilm’s tumour
- Osteosarcoma
- Ewing’s sarcoma
- Rhabdomyosarcoma
List three types of malignant primary bone tumour. Which is the most common?
- Osteosarcoma (most common)
- Chondrosarcoma
- Ewing’s sarcoma/PNET
What is an osteosarcoma, what age group is it most common in, and where does it tend to affect?
- Malignant bone-forming tumour of the bone that mainly occurs at the ends of long bones
- Tends to occur at age 10-30 years (incidence peaks in adolescence)
- 60% affect the knee
Describe the X-ray appearance of osteosarcoma
- Usually metaphyseal
- Lytic
- Permeative
- Elevated periosteum (Codman’s triangle)

Describe the histological appearance of osteosarcoma.
- Lots of malignant osteoblast cells with or without bone and cartilage formation
NOTE: this can be stained for using ALP

How can osteosarcoma be classified?
- Site within the bone (intramedullary, intracortical, surface)
- Degree of differentiation (high, intermediate, or low grade)
- Multicentricity
- Primary or secondary






